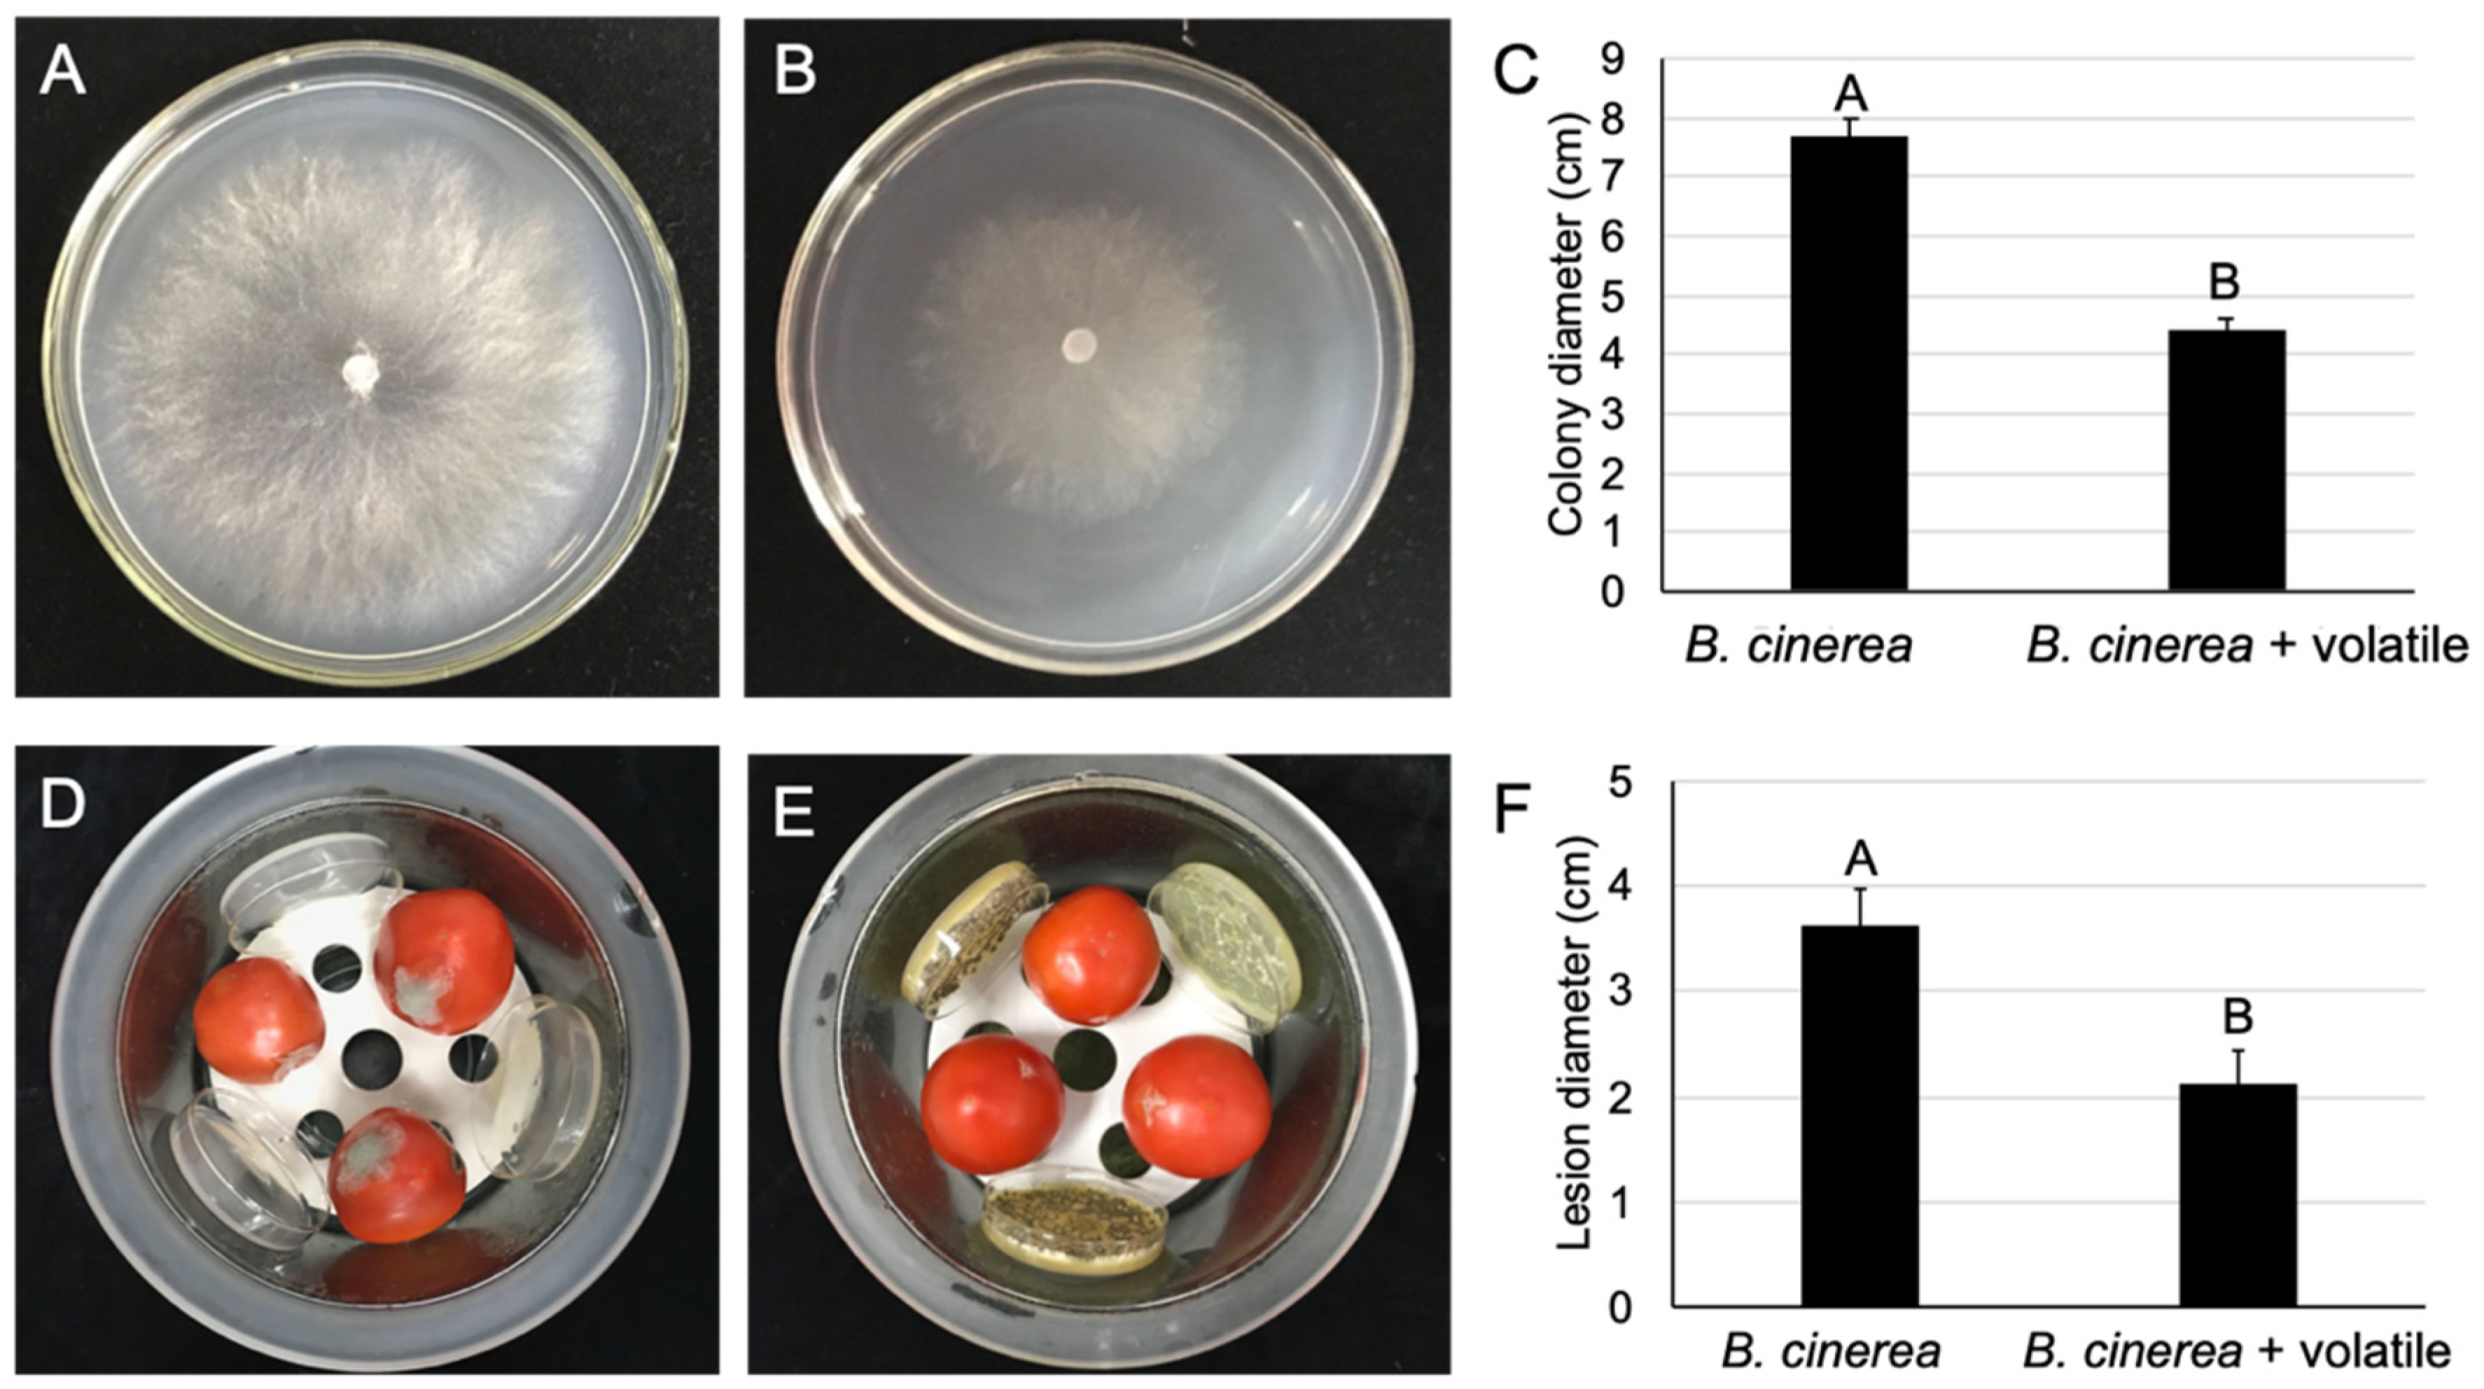
Pathogens 09 00213 g007

Biological Control of Tomato Gray Mold Caused by Botrytis Cinerea with the Entomopathogenic Fungus Metarhizium Anisopliae
Abstract
:1. Introduction
2. Results
2.1. The Antagonism of M. anisopliae against to B. cinerea
2.2. The M. anisopliae Culture Filtrate Influenced the Growth and Morphology of B. cinerea
2.3. The Culture Filtrate of M. anisopliae Affected the Sclerotia Germination of B. cinerea
2.4. The Culture Filtrate of M. anisopliae Inhibited Conidia Germination of B. cinerea
2.5. The Antifungal Substance Produced by M. anisopliae Retains Its Activity at High Temperatures
2.6. The Culture Filtrate of M. anisopliae Reduced the Gray Mold Severity of Detached Leaves and Fruits of the Tomato
2.7. The Volatile Organic Compounds of M. anisopliae Reduced the Gray Mold Severity of Postharvest Tomatoes
3. Discussion
4. Materials and Methods
4.1. Fungal Isolates and Cultural Condition
4.2. Assay Inhibitory Effect of M. anisopliae
4.3. Preparation of the Culture Filtrate of M. anisopliae
4.4. Effect of M. anisopliae Culture Filtrate against the Growth of B. cinerea
4.5. Effect of Culture Filtrate of M. anisopliae against the Germination of Conidia and Sclerotia of B. cinerea
4.6. Effect of Culture Filtrate of M. anisopliae on the Plasma Membrane Integrity of B. cinerea Conidia
4.7. Heat Stability of Culture Filtrate Activity of M. anisopliae
4.8. Sample Preparation for Transmission Electron Microscopy
4.9. Effect of Culture Filtrate on Gray Mold on Detached Tomato Leaves
4.10. Effect of Culture Filtrate of M. anisopliae on the Gray Mold of Ripe Tomato Fruits
4.11. Effect of Culture Filtrate of M. anisopliae against Tomato Plant Gray Mold
4.12. Volatile Effect of M. anisopliae on B. cinerea
4.13. Effect of M. anisopliae VOCs on Botrytis Gray Mold of Postharvest Tomatoes
4.14. Data Analysis
5. Conclusions
Author Contributions
Funding
Acknowledgments
Conflicts of Interest
References
- Agrios, G. Botrytis diseases. In Plant Pathology, 5th ed.; Dreibelbis, D., Ed.; Elsevier Academic Press: San Diego, CA, USA, 2005; pp. 510–514. [Google Scholar]
- Williamson, B.; Tudzynski, B.; Tudzynski, P.; van Kan, J.A. Botrytis cinerea: The cause of grey mould disease. Mol. Plant Pathol. 2007, 8, 561–580. [Google Scholar] [CrossRef]
- Elad, Y.; Pertot, I.; Prado, A.M.C.; Stewart, A. Plant hosts of Botrytis spp. In Botrytis–The Fungus, the Pathogen and Its Management in Agricultural Systems; Springer: Berlin/Heidelberg, Germany, 2016; pp. 413–486. [Google Scholar]
- Wang, J.; Xia, X.-M.; Wang, H.-Y.; Li, P.-P.; Wang, K.-Y. Inhibitory effect of lactoferrin against gray mould on tomato plants caused by Botrytis cinerea and possible mechanisms of action. Int. J. Food Microbiol. 2013, 161, 151–157. [Google Scholar] [CrossRef] [PubMed]
- Hua, L.; Yong, C.; Zhanquan, Z.; Boqiang, L.; Guozheng, Q.; Shiping, T. Pathogenic mechanisms and control strategies of Botrytis cinerea causing post-harvest decay in fruits and vegetables. Food Qual. Saf. 2018, 2, 111–119. [Google Scholar] [CrossRef] [Green Version]
- Elad, Y.; Williamson, B.; Tudzynski, P.; Delen, N. Botrytis spp. and diseases they cause in agricultural systems–an introduction. In Botrytis: Biology, Pathology and Control; Springer: Berlin/Heidelberg, Germany, 2007; pp. 1–8. [Google Scholar]
- Ciliberti, N.; Fermaud, M.; Roudet, J.; Rossi, V. Environmental conditions affect Botrytis cinerea infection of mature grape berries more than the strain or transposon genotype. Phytopathology 2015, 105, 1090–1096. [Google Scholar] [CrossRef] [PubMed] [Green Version]
- Elmer, P.A.; Michailides, T.J. Epidemiology of Botrytis cinerea in orchard and vine crops. In Botrytis: Biology, Pathology and Control; Springer: Berlin/Heidelberg, Germany, 2007; pp. 243–272. [Google Scholar]
- Adnan, M.; Hamada, M.; Li, G.; Luo, C. Detection and molecular characterization of resistance to the dicarboximide and benzamide fungicides in Botrytis cinerea from tomato in Hubei Province, China. Plant Dis. 2018, 102, 1299–1306. [Google Scholar] [CrossRef] [Green Version]
- Myresiotis, C.; Karaoglanidis, G.; Tzavella-Klonari, K. Resistance of Botrytis cinerea isolates from vegetable crops to anilinopyrimidine, phenylpyrrole, hydroxyanilide, benzimidazole, and dicarboximide fungicides. Plant Dis. 2007, 91, 407–413. [Google Scholar] [CrossRef] [Green Version]
- Mosbach, A.; Edel, D.; Farmer, A.D.; Widdison, S.; Barchietto, T.; Dietrich, R.A.; Corran, A.; Scalliet, G. Anilinopyrimidine resistance in Botrytis cinerea is linked to mitochondrial function. Front. Microbiol. 2017, 8, 2361. [Google Scholar] [CrossRef]
- Adnan, M.; Hamada, M.S.; Hahn, M.; Li, G.-Q.; Luo, C.-X. Fungicide resistance of Botrytis cinerea from strawberry to procymidone and zoxamide in Hubei, China. Phytopathol. Res. 2019, 1, 17. [Google Scholar] [CrossRef]
- Kretschmer, M.; Leroch, M.; Mosbach, A.; Walker, A.-S.; Fillinger, S.; Mernke, D.; Schoonbeek, H.-J.; Pradier, J.-M.; Leroux, P.; De Waard, M.A. Fungicide-driven evolution and molecular basis of multidrug resistance in field populations of the grey mould fungus Botrytis cinerea. PLoS Pathog. 2009, 5, e1000696. [Google Scholar] [CrossRef]
- Rosero-Hernández, E.D.; Moraga, J.; Collado, I.G.; Echeverri, F. Natural compounds that modulate the development of the fungus Botrytis cinerea and protect Solanum lycopersicum. Plants 2019, 8, 111. [Google Scholar] [CrossRef] [Green Version]
- Abbey, J.A.; Percival, D.; Abbey, L.; Asiedu, S.K.; Prithiviraj, B.; Schilder, A. Biofungicides as alternative to synthetic fungicide control of grey mould (Botrytis cinerea)–prospects and challenges. Biocontrol. Sci. Technol. 2019, 29, 207–228. [Google Scholar] [CrossRef]
- Aqueveque, P.; Céspedes, C.L.; Becerra, J.; Aranda, M.; Sterner, O. Antifungal activities of secondary metabolites isolated from liquid fermentations of Stereum hirsutum (Sh134-11) against Botrytis cinerea (grey mould agent). Food Chem. Toxicol. 2017, 109, 1048–1054. [Google Scholar] [CrossRef] [PubMed]
- Kasfi, K.; Taheri, P.; Jafarpour, B.; Tarighi, S. Identification of epiphytic yeasts and bacteria with potential for biocontrol of grey mold disease on table grapes caused by Botrytis cinerea. Span. J. Agric. Res. 2018, 16, 1002. [Google Scholar] [CrossRef]
- Calvo-Garrido, C.; Roudet, J.; Aveline, N.; Davidou, L.; Dupin, S.; Fermaud, M. Microbial antagonism toward Botrytis bunch rot of grapes in multiple field tests using one Bacillus ginsengihumi strain and formulated biological control products. Front. Plant Sci. 2019, 10. [Google Scholar] [CrossRef]
- Mulero-Aparicio, A.; Cernava, T.; Turra, D.; Schaefer, A.; Pietro, A.D.; Escudero, F.J.L.; Trapero, A.; Berg, G. The role of volatile organic compounds and rhizosphere competence in the mode of action of the non-pathogenic Fusarium oxysporum FO12 towards Verticillium wilt. Front. Microbiol. 2019, 10, 1808. [Google Scholar] [CrossRef] [Green Version]
- Chen, X.; Wang, Y.; Gao, Y.; Gao, T.; Zhang, D. Inhibitory abilities of Bacillus isolates and their culture filtrates against the gray mold caused by Botrytis cinerea on postharvest fruit. Plant Pathol. J. 2019, 35, 425. [Google Scholar]
- Köhl, J.; Kolnaar, R.; Ravensberg, W.J. Mode of action of microbial biological control agents against plant diseases: Relevance beyond efficacy. Front. Plant Sci. 2019, 10, 845. [Google Scholar] [CrossRef] [Green Version]
- Mhlongo, M.I.; Piater, L.A.; Madala, N.E.; Labuschagne, N.; Dubery, I.A. The chemistry of plant–microbe interactions in the rhizosphere and the potential for metabolomics to reveal signaling related to defense priming and induced systemic resistance. Front. Plant Sci. 2018, 9, 112. [Google Scholar] [CrossRef] [Green Version]
- Kassa, A.; Stephan, D.; Vidal, S.; Zimmermann, G. Production and processing of Metarhizium anisopliae var. acridum submerged conidia for locust and grasshopper control. Mycol. Res. 2004, 108, 93–100. [Google Scholar] [CrossRef]
- Abdel-Raheem, M.; Al-Keridis, L.A. Virulence of three entomopathogenic fungi against whitefly, Bemisia tabaci (Gennadius) (Hemiptera: Aleyrodidae) in tomato crop. J. Entomol. 2017, 14, 155–159. [Google Scholar]
- Kivett, J.; Cloyd, R.; Bello, N. Evaluation of entomopathogenic fungi against the western flower thrips (Thysanoptera: Thripidae) under laboratory conditions. J. Entomol. Sci. 2016, 51, 274–291. [Google Scholar] [CrossRef]
- Nardoni, S.; Ebani, V.V.; D’Ascenzi, C.; Pistelli, L.; Mancianti, F. Sensitivity of entomopathogenic fungi and bacteria to plants secondary metabolites, for an alternative control of Rhipicephalus (Boophilus) microplus in cattle. Front. Pharmacol. 2018, 9, 937. [Google Scholar] [CrossRef] [PubMed]
- Jaber, L.R.; Ownley, B.H. Can we use entomopathogenic fungi as endophytes for dual biological control of insect pests and plant pathogens? Biol. Control 2018, 116, 36–45. [Google Scholar] [CrossRef]
- Gao, Q.; Jin, K.; Ying, S.-H.; Zhang, Y.; Xiao, G.; Shang, Y.; Duan, Z.; Hu, X.; Xie, X.-Q.; Zhou, G. Genome sequencing and comparative transcriptomics of the model entomopathogenic fungi Metarhizium anisopliae and M. acridum. PLoS Genet. 2011, 7, e1001264. [Google Scholar] [CrossRef] [Green Version]
- Vyas, N.; Dua, K.; Prakash, S. Larvicidal activity of metabolites of Metarhizium anisopliae against aedes and culex mosquitoes. Entomol. Ornithol. Herpetol. 2015, 4, 1. [Google Scholar] [CrossRef] [Green Version]
- Isaka, M.; Kittakoop, P.; Kirtikara, K.; Hywel-Jones, N.L.; Thebtaranonth, Y. Bioactive substances from insect pathogenic fungi. Acc. Chem. Res. 2005, 38, 813–823. [Google Scholar] [CrossRef]
- Yun, H.-G.; Kim, D.-J.; Gwak, W.-S.; Shin, T.-Y.; Woo, S.-D. Entomopathogenic fungi as dual control agents against both the pest Myzus persicae and phytopathogen Botrytis cinerea. Mycobiology 2017, 45, 192–198. [Google Scholar] [CrossRef] [Green Version]
- Shin, T.Y.; Bae, S.M.; Woo, S.D. Screening and characterization of antimicrobial substances originated from entomopathogenic fungi. J. Asia Pac. Entomol. 2016, 19, 1053–1059. [Google Scholar] [CrossRef]
- Dean, R.; Van Kan, J.A.; Pretorius, Z.A.; Hammond-Kosack, K.E.; Di Pietro, A.; Spanu, P.D.; Rudd, J.J.; Dickman, M.; Kahmann, R.; Ellis, J. The Top 10 fungal pathogens in molecular plant pathology. Mol. Plant Pathol. 2012, 13, 414–430. [Google Scholar] [CrossRef] [Green Version]
- Vos, C.M.; De Cremer, K.; Cammue, B.P.; De Coninck, B. The toolbox of Trichoderma spp. in the biocontrol of Botrytis cinerea disease. Mol. Plant Pathol. 2015, 16, 400–412. [Google Scholar] [CrossRef] [Green Version]
- Paulitz, T.C.; Bélanger, R.R. Biological control in greenhouse systems. Annu. Rev. Phytopathol. 2001, 39, 103–133. [Google Scholar] [CrossRef] [PubMed]
- Jaber, L.R. Seed inoculation with endophytic fungal entomopathogens promotes plant growth and reduces crown and root rot (CRR) caused by Fusarium culmorum in wheat. Planta 2018, 248, 1525–1535. [Google Scholar] [CrossRef] [PubMed]
- Schrank, A.; Vainstein, M.H. Metarhizium anisopliae enzymes and toxins. Toxicon 2010, 56, 1267–1274. [Google Scholar] [CrossRef] [PubMed]
- Freimoser, F.M.; Hu, G.; St Leger, R.J. Variation in gene expression patterns as the insect pathogen Metarhizium anisopliae adapts to different host cuticles or nutrient deprivation in vitro. Microbiology 2005, 151, 361–371. [Google Scholar] [CrossRef] [PubMed] [Green Version]
- Baek, J.-M.; Howell, C.R.; Kenerley, C.M. The role of an extracellular chitinase from Trichoderma virens Gv29-8 in the biocontrol of Rhizoctonia solani. Curr. Genet. 1999, 35, 41–50. [Google Scholar] [CrossRef] [PubMed]
- Limón, M.; Chacón, M.; Mejías, R.; Delgado-Jarana, J.; Rincón, A.; Codón, A.; Benítez, T. Increased antifungal and chitinase specific activities of Trichoderma harzianum CECT 2413 by addition of a cellulose binding domain. Appl. Microbiol. Biotechnol. 2004, 64, 675–685. [Google Scholar] [CrossRef]
- Viterbo, A.; Haran, S.; Friesem, D.; Ramot, O.; Chet, I. Antifungal activity of a novel endochitinase gene (chit36) from Trichoderma harzianum Rifai TM. FEMS Microbiol. Lett. 2001, 200, 169–174. [Google Scholar] [CrossRef]
- Wu, Q.; Bai, L.; Liu, W.; Li, Y.; Lu, C.; Li, Y.; Fu, K.; Yu, C.; Chen, J. Construction of a Streptomyces lydicus A01 transformant with a chit42 gene from Trichoderma harzianum P1 and evaluation of its biocontrol activity against Botrytis cinerea. J. Microbiol. 2013, 51, 166–173. [Google Scholar] [CrossRef]
- Sbaraini, N.; Guedes, R.L.M.; Andreis, F.C.; Junges, Â.; de Morais, G.L.; Vainstein, M.H.; de Vasconcelos, A.T.R.; Schrank, A. Secondary metabolite gene clusters in the entomopathogen fungus Metarhizium anisopliae: Genome identification and patterns of expression in a cuticle infection model. BMC Genom. 2016, 17, 736. [Google Scholar] [CrossRef] [Green Version]
- Mburu, D.M.; Ndung’u, M.W.; Maniania, N.K.; Hassanali, A. Comparison of volatile blends and gene sequences of two isolates of Metarhizium anisopliae of different virulence and repellency toward the termite Macrotermes michaelseni. J. Exp. Biol. 2011, 214, 956–962. [Google Scholar] [CrossRef] [Green Version]
- Liu, L.; Li, G.; Sun, P.; Lei, C.; Huang, Q. Experimental verification and molecular basis of active immunization against fungal pathogens in termites. Sci. Rep. 2015, 5, 15106. [Google Scholar] [CrossRef] [PubMed]
- Zhou, Y.; Li, N.; Yang, J.; Yang, L.; Wu, M.; Chen, W.; Li, G.; Zhang, J. Contrast between orange-and black-colored sclerotial isolates of Botrytis cinerea: Melanogenesis and ecological fitness. Plant Dis. 2018, 102, 428–436. [Google Scholar] [CrossRef] [PubMed] [Green Version]
- Potgieter, C.A.; Castillo, A.; Castro, M.; Cottet, L.; Morales, A. A wild-type Botrytis cinerea strain co-infected by double-stranded RNA mycoviruses presents hypovirulence-associated traits. Virol. J. 2013, 10, 220. [Google Scholar] [CrossRef] [PubMed] [Green Version]
- Yu, L.; Sang, W.; Wu, M.-D.; Zhang, J.; Yang, L.; Zhou, Y.-J.; Chen, W.-D.; Li, G.-Q. Novel hypovirulence-associated RNA mycovirus in the plant-pathogenic fungus Botrytis cinerea: Molecular and biological characterization. Appl. Environ. Microbiol. 2015, 81, 2299–2310. [Google Scholar] [CrossRef] [PubMed] [Green Version]
- Singh, D.; Singh, R.; Salisbury, P.; Barbetti, M. Genetic diversity in Australian, Indian and Chinese oilseed Brassica germplasm against sclerotinia-rot resistance. In Proceedings of the International Rapeseed Congress, Prague, Crech Republic, 5–9 June 2011. [Google Scholar]
- Shakeel, Q.; Lyu, A.; Zhang, J.; Wu, M.; Li, G.; Hsiang, T.; Yang, L. Biocontrol of Aspergillus flavus on peanut kernels using Streptomyces yanglinensis 3–10. Front. Microbiol. 2018, 9, 1049. [Google Scholar] [CrossRef] [Green Version]
- Boukaew, S.; Prasertsan, P.; Troulet, C.; Bardin, M. Biological control of tomato gray mold caused by Botrytis cinerea by using Streptomyces spp. Biocontrol 2017, 62, 793–803. [Google Scholar] [CrossRef]
- Vicedo, B.; de la O Leyva, M.; Flors, V.; Finiti, I.; Del Amo, G.; Walters, D.; Real, M.D.; García-Agustín, P.; González-Bosch, C. Control of the phytopathogen Botrytis cinerea using adipic acid monoethyl ester. Arch. Microbiol. 2006, 184, 316–326. [Google Scholar] [CrossRef]
- Youssef, K.; Roberto, S.R.; de Oliveira, A.G. Ultra-structural alterations in Botrytis cinerea—the causal agent of gray mold—treated with salt solutions. Biomolecules 2019, 9, 582. [Google Scholar] [CrossRef] [Green Version]
- Yang, F.; Abdelnabby, H.; Xiao, Y. A mutant of the nematophagous fungus Paecilomyces lilacinus (Thom) is a novel biocontrol agent for Sclerotinia sclerotiorum. Microb. Pathog. 2015, 89, 169–176. [Google Scholar] [CrossRef]
- Kang, Z. Ultrastructure of Plant Pathogenic Fungi; China Science & Technology Press: Beijing, China, 1996. [Google Scholar]
- Wang, S.; Ruan, C.; Yi, L.; Deng, L.; Yao, S.; Zeng, K. Biocontrol ability and action mechanism of Metschnikowia citriensis against Geotrichum citri-aurantii causing sour rot of postharvest citrus fruit. Food Microbiol. 2020, 87, 103375. [Google Scholar] [CrossRef]
- Gao, P.; Qin, J.; Li, D.; Zhou, S. Inhibitory effect and possible mechanism of a Pseudomonas strain QBA5 against gray mold on tomato leaves and fruits caused by Botrytis cinerea. PLoS ONE 2018, 13, e0190932. [Google Scholar] [CrossRef] [PubMed] [Green Version]
- Liu, Y.; Yao, S.; Deng, L.; Ming, J.; Zeng, K. Different mechanisms of action of isolated epiphytic yeasts against Penicillium digitatum and Penicillium italicum on citrus fruit. Postharvest Biol. Technol. 2019, 152, 100–110. [Google Scholar] [CrossRef]
- Huang, R.; Li, G.; Zhang, J.; Yang, L.; Che, H.; Jiang, D.; Huang, H. Control of postharvest Botrytis fruit rot of strawberry by volatile organic compounds of Candida intermedia. Phytopathology 2011, 101, 859–869. [Google Scholar] [CrossRef] [PubMed] [Green Version]

| Treatment | Average Germination Rate (%) | % Relative Inhibition of Sclerotia Germination |
|---|---|---|
| Control | 96.89 ± 2.13 A | - |
| 10% culture filtrate treated | 35.04 ± 1.69 B | 63.85 ± 1.16 |
© 2020 by the authors. Licensee MDPI, Basel, Switzerland. This article is an open access article distributed under the terms and conditions of the Creative Commons Attribution (CC BY) license (http://creativecommons.org/licenses/by/4.0/).
Share and Cite
Sarven, M.S.; Hao, Q.; Deng, J.; Yang, F.; Wang, G.; Xiao, Y.; Xiao, X. Biological Control of Tomato Gray Mold Caused by Botrytis Cinerea with the Entomopathogenic Fungus Metarhizium Anisopliae. Pathogens 2020, 9, 213. https://doi.org/10.3390/pathogens9030213
Sarven MS, Hao Q, Deng J, Yang F, Wang G, Xiao Y, Xiao X. Biological Control of Tomato Gray Mold Caused by Botrytis Cinerea with the Entomopathogenic Fungus Metarhizium Anisopliae. Pathogens. 2020; 9(3):213. https://doi.org/10.3390/pathogens9030213
Chicago/Turabian StyleSarven, Most.Sinthia, Qiuyan Hao, Junbo Deng, Fang Yang, Gaofeng Wang, Yannong Xiao, and Xueqiong Xiao. 2020. "Biological Control of Tomato Gray Mold Caused by Botrytis Cinerea with the Entomopathogenic Fungus Metarhizium Anisopliae" Pathogens 9, no. 3: 213. https://doi.org/10.3390/pathogens9030213
APA StyleSarven, M. S., Hao, Q., Deng, J., Yang, F., Wang, G., Xiao, Y., & Xiao, X. (2020). Biological Control of Tomato Gray Mold Caused by Botrytis Cinerea with the Entomopathogenic Fungus Metarhizium Anisopliae. Pathogens, 9(3), 213. https://doi.org/10.3390/pathogens9030213





